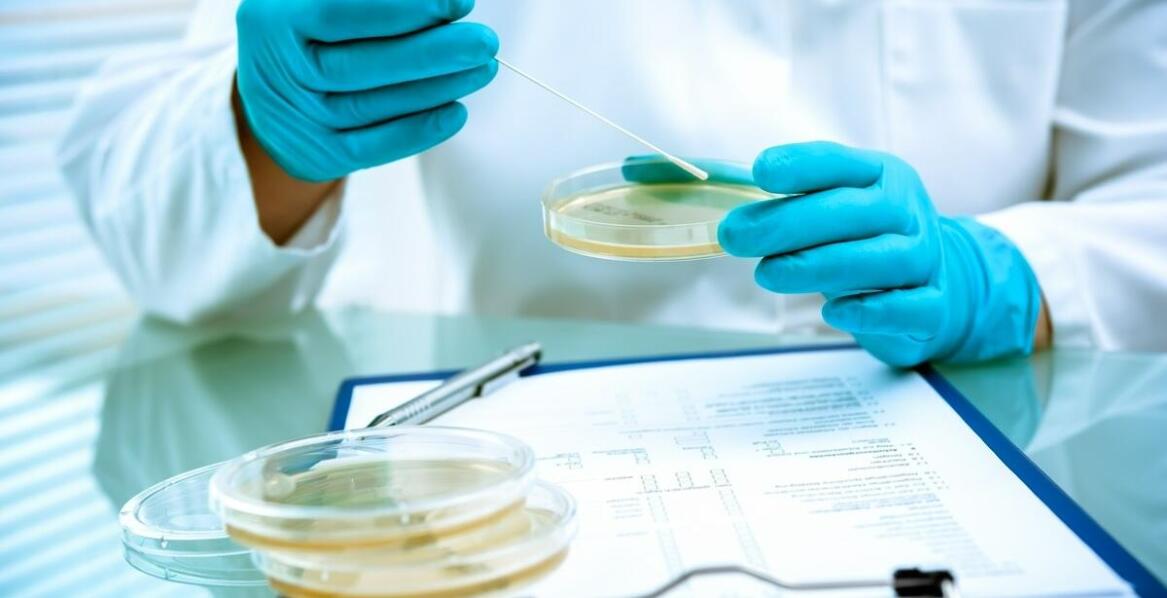
Czym jest ekspertyza mykologiczna i jakie problemy może wykryć w budynkach

Transport i logistyka w jednym miejscu
Szukasz informacji o transporcie, logistyce, czy nowych pojazdach? Znajdziesz je tutaj!
Czym jest ekspertyza mykologiczna i jakie problemy może wykryć w budynkach
Ekspertyza mykologiczna to specjalistyczne badanie, które wykrywa i identyfikuje grzyby oraz pleśnie w budynkach, ocenia ich wpływ na konstrukcję i zdrowie mieszkańców oraz wskazuje konkretne działania naprawcze. W praktyce pozwala szybko ustalić źródło wilgoci, potwierdzić rodzaj zakażenia biologic

Pasy klinowe jako klucz do efektywności przemysłowej

Czy suplementy diety na alergie mogą zastąpić leki przeciwhistaminowe?
Artykuły ostatnio dodane
Usługi i produkty remontowo-budowlane

Wybór odpowiedniego koloru parapetu do tradycyjnych i nowoczesnych domów
Wybór koloru parapetów zewnętrznych ma istotne znaczenie dla estetyki i harmonii budynku. Odpowiednio dobrany odcień podkreśla styl architektoniczny oraz współgra z fasadą i otoczeniem. W artykule omówimy, jak dobrać kolor do tradycyjnych i nowoczesnych domów, zwracając uwagę na różnice w podejściu
Transport, logistyka i pojazdy

Wymiana filtrów, olejów i płynów eksploatacyjnych - jak często należy to robić?
Dbanie o samochód to nie tylko regularne mycie i sprawdzanie stanu opon, ale także wymiana filtrów, olejów i płynów eksploatacyjnych. Właściwa konserwacja tych elementów wpływa na dłuższą żywotność pojazdu oraz bezpieczeństwo jazdy. Warto zatem wiedzieć, jak często powinniśmy dokonywać wymiany tych
Ochrona zdrowia i uroda

Rola endokrynologa w monitorowaniu dzieci z hipotrofią płodu i zespołem Downa
Wczesna diagnoza odgrywa kluczową rolę w monitorowaniu dzieci z hipotrofia płodu oraz zespołem Downa. Umożliwia szybsze wprowadzenie odpowiednich interwencji medycznych, które mogą pozytywnie wpłynąć na rozwój malucha. Specyfika potrzeb zdrowotnych tych pacjentów wymaga współpracy z innymi specjalis
Produkty i usługi dla każdego

Jak dobrać odpowiednie kolory i materiały do haftowania na sztandarach?
Znaczenie kolorów i materiałów w haftowaniu sztandarów odgrywa kluczową rolę, gdyż wpływa na ostateczny wygląd i jakość wykonania. Właściwy dobór tych elementów jest niezbędny, aby stworzyć produkt spełniający oczekiwania klienta. Firma zajmująca się szyciem i haftowaniem sztandarów oraz strojów lud
Finanse i ubezpieczenia

Uproszczone rozliczenia a pełna księgowość: co wybrać dla swojej działalności?
Wybór odpowiedniego systemu księgowego ma kluczowe znaczenie dla efektywności zarządzania finansami w firmie. Różnice między uproszczonymi rozliczeniami a pełną księgowością dotyczą skomplikowania, kosztów oraz wymagań prawnych. Właściwy wybór może znacząco wpłynąć na oszczędność czasu i zasobów, a
Odzież, obuwie i dodatki

Oryginalne wzory pikowania tkanin - inspiracje dla projektantów
Pikowane tkaniny od dawna cieszą się dużym zainteresowaniem wśród projektantów oraz klientów. Dzięki swojej wyjątkowej strukturze i oryginalnym wzorom, tkaniny pikowane doskonale sprawdzają się zarówno w produkcji odzieży, jak i artykułów dekoracyjnych czy meblowych. Hurtownia tkanin pikowanych ofer
Elektronika, AGD, narzędzia

Z czego wynika popularność drink barów na weselach?
Wzrost popularności drink barów na weselach wynika z chęci par młodych do zapewnienia gościom niezapomnianych wrażeń. Mobilne usługi barmańskie umożliwiają dostosowanie oferty do indywidualnych potrzeb, co sprawia, że wesele staje się bardziej atrakcyjne. Oprócz standardowych drinków uczestnicy mogą
Nauka i szkolnictwo

Jak wyroby ze stali kwasoodpornej zwiększają trwałość konstrukcji?
Stal kwasoodporna odgrywa istotną rolę w budownictwie dzięki swoim wyjątkowym właściwościom. Charakteryzuje się odpornością na korozję, co sprawia, że konstrukcje są trwałe i estetyczne. Wytrzymałość mechaniczna oraz atrakcyjny wygląd to kolejne zalety tego materiału. Zastosowanie wyrobów ze stali k
Gastronomia, artykuły spożywcze

Jakie innowacje technologiczne pomagają w eliminowaniu rozwarstwienia polewy czekoladowej?
Innowacje w produkcji czekolady odgrywają kluczową rolę w eliminowaniu problemu rozwarstwienia polewy czekoladowej, co ma istotne znaczenie dla jakości produktów cukierniczych oraz spełnienia oczekiwań konsumentów. Współczesne technologie umożliwiają uzyskanie jednolitej i trwałej konsystencji polew
Turystyka, noclegi i wypoczynek

Kolejka Izerska: fascynująca podróż przez malownicze krajobrazy
Kolejka Izerska to nie tylko środek transportu, ale także wyjątkowa atrakcja turystyczna, która oferuje niezapomniane widoki i emocje. W naszej części przybliżymy historię tego środka komunikacji, jego znaczenie dla regionu oraz unikalne doświadczenia, jakie oferuje podróżującym. Zobaczymy, jak łącz
Wnętrza - wyposażenie i wystrój

Honownica do tulei jako niezbędne narzędzie w warsztacie meblarskim
Honownica do tulei odgrywa kluczową rolę w obróbce drewna, zwłaszcza podczas produkcji mebli. To narzędzie umożliwia precyzyjne i efektywne wykonywanie prac, co przekłada się na wysoką jakość wyrobów stolarskich. W warsztatach meblarskich honownica jest niezbędna dla każdego stolarza, a jej zastosow
Media i badanie rynku

Jak zdjęcia produktowe mogą wspierać strategię marketingową firmy?
W dzisiejszym świecie marketingu wizualnego zdjęcia produktowe odgrywają kluczową rolę w przyciąganiu uwagi klientów. Estetyka oraz profesjonalizm prezentacji mają istotny wpływ na decyzje zakupowe. Odpowiednio dobrane fotografie mogą wspierać strategię marketingową firmy, zwiększając jej konkurency
Zakupy, kultura i rozrywka

Jakie środki bezpieczeństwa są stosowane podczas skoków w tandemie?
Skoki spadochronowe w tandemie to ekscytujące doświadczenie, które przyciąga wielu miłośników adrenaliny. Jednak bezpieczeństwo jest kluczowe w tym sporcie. W artykule omówimy środki podejmowane w celu ochrony uczestników oraz rolę wykwalifikowanych instruktorów i sprzętu spadochronowego. Dzięki tem
Instytucje, organizacje i stowarzyszenia

Rola stowarzyszeń w integracji społecznej różnych grup wiekowych
Stowarzyszenia są niezbędne dla integracji społecznej, łącząc różne grupy wiekowe i wspierając ich współpracę. Ich znaczenie w budowaniu więzi międzyludzkich oraz promowaniu aktywności społecznej jest ogromne. W artykule przedstawiono, jak te organizacje wpływają na rozwój lokalnych społeczności pop
Rolnictwo, zwierzęta i rośliny

Jak odpowiednia suplementacja może wpłynąć na kondycję gołębi podczas pierzenia?
Suplementacja gołębi jest szczególnie istotna w okresie pierzenia, gdy ptaki potrzebują dodatkowych składników odżywczych. Odpowiednie preparaty wspierają zdrowie i kondycję tych ptaków, zapobiegając chorobom oraz wspomagając naturalne procesy organizmu. Warto zwrócić uwagę na suplementy dla gołębi,
Nieruchomości, zarządzanie budynkami i obiektami

Jak pośrednik nieruchomości ułatwia proces zakupu mieszkania?
Specjalista odgrywa kluczową rolę w uproszczeniu zakupu mieszkania, oferując szereg korzyści. Dzięki współpracy z profesjonalistą można zaoszczędzić czas, korzystając z jego doświadczenia oraz wiedzy o rynku. Pośrednik nieruchomości zapewnia dostęp do bogatej oferty mieszkań i wspiera w negocjacjach